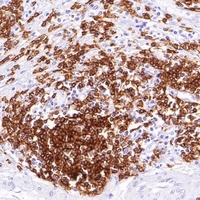
Goat Mouse IgG (H&L)-HRP Polymer Antibody

You have no items in your shopping cart.
Goat Rabbit IgG (H&L)-HRP Polymer Antibody
Description
Images & Validation
−| Tested Applications | ELISA, ICC, IHC, WB |
|---|---|
| Dilution range | E (1/5000 - 1/20000), WB (1/5000 - 1/20000), IH (1/100 - 1/500), IC (1/100 - 1/500) |
| Reactivity | Rabbit |
Key Properties
−| Antibody Type | Secondary Antibody |
|---|---|
| Host | Goat |
| Clonality | Polyclonal |
| Immunogen | Rabbit IgG |
| Purification | Goat Polyclonal Secondary Antibody to Rabbit IgG (H&L) have been cross-adsorbed against IgG from bovine, goat, guinea pig, hamster, horse, mouse, rat, and human. Cross-adsorption or pre-adsorption is a purification step to increase specificity of the antibody resulting in less background staining and cross-reactivity. The secondary antibody solution is passed through a column matrix containing immobilized serum proteins from potentially cross-reactive species. Only the nonspecific-binding secondary antibodies are captured in the column, and the highly specific secondaries flow through. Further passages through additional columns result in highly cross-adsorbed preparations of secondary antibody. The benefits of these extra steps are apparent in multiplexing/multicolor-staining experiments where there is potential cross-reactivity with other primary antibodies or in tissue/cell fluorescent staining experiments where there may be the presence of endogenous immunoglobulins. |
| Conjugation | HRP |
Storage & Handling
−| Storage | Shipped at 4°C. Upon delivery aliquot and store at -20°C for one year. Avoid freeze/thaw cycles. |
|---|---|
| Form/Appearance | 0.5 mg/ml. Liquid in 0.01M Phosphate Buffered Saline, pH 7.2, containing 1% rAlbumin, 50% glycerol, 0.05% Proclin |
| Disclaimer | For research use only |
Similar Products
−Goat Mouse/Rabbit IgG (H&L)-HRP Polymer (Ready to use) Antibody [orb1878754]
ELISA, ICC, IHC, WB
Mouse, Rabbit
Goat
Polyclonal
HRP
10 ml, 100 mlGoat Mouse/Rabbit IgG (H&L)-HRP Polymer Antibody [orb1878757]
ELISA, ICC, IHC, WB
Mouse, Rabbit
Goat
Polyclonal
HRP
1 ml, 500 μl, 100 μlGoat Rabbit IgG (H&L)-HRP Polymer (Ready to use) Antibody [orb1878755]
ELISA, ICC, IHC, WB
Rabbit
Goat
Polyclonal
HRP
10 ml, 100 mlGoat Mouse IgG (H&L)-HRP Polymer (Ready to use) Antibody [orb1878756]
ELISA, ICC, IHC, WB
Mouse
Goat
Polyclonal
HRP
10 ml, 100 mlGoat Mouse IgG (H&L)-HRP Polymer Antibody [orb1878759]
ELISA, ICC, IHC, WB
Mouse
Goat
Polyclonal
HRP
500 μl, 1 ml, 100 μl

Quality Guarantee
Explore bioreagents carefree to elevate your research. All our products are rigorously tested for performance. If a product does not perform as described on its datasheet, our scientific support team will provide expert troubleshooting, a prompt replacement, or a refund. For full details, please see our Terms & Conditions and Buying Guide. Contact us at support@biorbyt.com.

Immunohistochemical analysis staining in human liver carcinoma formalin fixed paraffin-embedded tissue section. The section was pre-treated using pressure cooker heat antigen retrieval with sodium citrate buffer (0.01 M, pH = 6) for 3 minutes. The section was detected using rabbit primary antibody, and Goat Anti-Rabbit IgG (H&L)-HRP polymer. The section was then counterstained with haematoxylin and mounted with Neutral Gum.
Quick Database Links
Documents Download
Request a Document
Protocol Information
Goat Rabbit IgG (H&L)-HRP Polymer Antibody (orb1878758)
Participating in our Biorbyt product reviews program enables you to support fellow scientists by sharing your firsthand experience with our products.
Login to Submit a Review